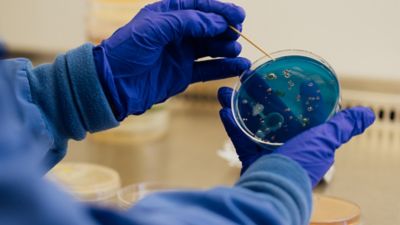
Scientist Examining Bacterial Growth in Petri Dish

Country Selector
Please enter a valid location
Bridging the Ag Innovation and Communication Gap
The need for greater agricultural production across the globe continues to rise, with some estimates predicting a 50%-60% increase in total global food demand between 2019 and 2050. At the same time, there is growing public interest and desire to know more about technology used in agriculture. Whether it’s antibiotics in livestock production, GMOs in row crops or the latest herbicide, one thing is for certain — more people want to understand technology and how it is used to benefit farming and society as a whole. What happens when public acceptance of ag technology slows? Release of new innovations may slow, farmers’ ability to effectively control pests could wane, yields per acre could stagnate, export markets might constrain and so on. As technology providers, it’s important that we collaborate to help ensure understanding and awareness so that consumers have answers to their questions and understand the benefits of ag tech. This ultimately benefits farmers that produce ag products and the consumers that rely on those products for food, clothing and energy in their daily lives. But how can we do this? The answer lies at the intersection of innovation and communication.
The roots of resistance to innovation
As with all new things, it can take time to build understanding and acceptance. Dr. Kevin Folta, professor of horticultural sciences at the University of Florida, has spent decades studying plant development, physiology and metabolism, as well as how to communicate scientific topics to the public. At the 2025 ASTA Field Crop Seed Convention, Dr. Folta explained several of the reasons why the public is resistant to agricultural innovation. First, people generally don’t like change. Second, food occupies a special social and emotional place for most of us. So, changes to such an important part of peoples’ lives can cause immediate hesitation and skepticism. When you couple those issues with the fact that many people don’t always believe in science and are exposed to a great deal of disinformation on social media, mere science, fact, reason, logic and good data might not be enough to overcome it.
Winning hearts and minds with effective communication
So, what is the solution? It clearly isn’t more research or information. If it were, all the scientific publications detailing ag tech innovation and its favorable results would ensure public acceptance. What’s needed is effective communication that allows people to relate to the technology or innovation in a way that makes sense to them and establishes trust. Here are a few tips that can help you engage with your audience:
- Start by sharing common values, common concerns and things that are important to you (not the facts and figures). Talk about what you worry about regarding your family and yourself, such as your own health or your own environment. This gives people the opportunity to connect and learn slowly, to understand that maybe the science is attached to something that can benefit them.
- Then, explain more about what you do and why it’s important— for the environment, to help feed people, to help ensure American farmers remain profitable, to do all this sustainably. These types of nearly universal values help unite us rather than divide us, and that helps build trust.
- When sharing information about a particular product or technology, don’t try to sell or persuade your audience. Keep the conversation factual and neutral. Avoid any arguments and always take the high road. Refer people to relevant third-party sources, such as colleges and universities, government institutions or credible news organizations, so they can learn more on their own.
- It’s also important to show up in the appropriate places where these conversations about agricultural innovation are happening — social media, comment sections of news stories, community meetings, etc. Positively reaching just a few people can have a compounding effect as they reach others, and those others reach even more people.
Overcoming social resistance to innovation starts with meeting people where they are. By showing up in everyday spaces, talking about why we innovate for healthier families and environments and building trust through gradual, relatable conversations. This isn’t just about feeding nine billion people by 2050, it’s about fostering public understanding in a way that provides room for innovations that have the potential to significantly change people's lives for the better. Technology that can do things more efficiently and sustainably. Breakthroughs that one day may help solve humanity’s greatest challenges. It’s a big task. But if anyone can do it, it’s farmers. And all those who support them.
™ Trademarks of Corteva Agriscience and its affiliated companies. © 2026 Corteva. 034062 LC (04/26)

